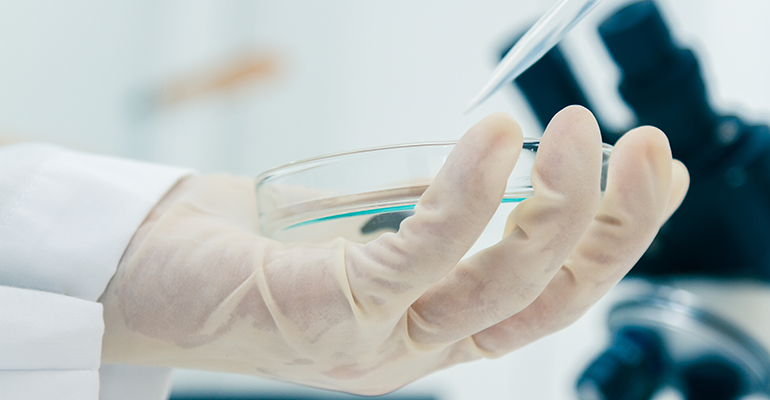

Ingredients Categories
Finished Products
Finished Food Categories
- Bakery
- Beverages / Juices
- Cereal and grain products
- Confectionery
- Cooking Fats & Oils
- Dairy
- Egg products
- Fruits & Vegetables
- Infant & Baby food
- Meat, Poultry & Fish
- Nuts & Seeds products
- Other Finished Food Categories
- Pet Food
- Plant-based foods
- Prepared foods
- Sauces & Seasonings
- Sweet & Savoury Spreads
Health & Wellness Areas
Delivery Formats
Operations & Services
- 3D printing
- Analysis/ Testing
- Auditing & certifications
- Blending & mixing
- Bottling
- Certification
- Clinical Trials
- Co-packing
- Coating
- Consulting
- Contract manufacturing
- Drying
- Electrospinning
- Encapsulating
- Enzymatic processing
- Extracting
- Extrusion
- Fat structuring
- Fermentation
- Filling
- Flavour development
- Freeze Drying
- Granulating/ grinding/ milling / mixing
- High pressure processing
- Labelling
- Other Operations & Services
- Packaging
- Packet filling
- Pasturising
- Quality assurance
- Saccharification
- Sheer cell processing
- Spray drying
- Sterilisation
- Storage & Logistics
- Tabletting
- Toasting / roasting
- Ultra-high temperature processing
News
Alt-protein dip not enough to distract consumers from meat replacement realties
12 Jan 2024
Despite a recent downturn in alt-protein’s fortunes, consumers haven’t lost faith in the idea of cultivated meats and plant-based food becoming a permanent fixture in diets of the future, according to Alex Mayers, managing director of the Good Food Institute (GFI) for Europe.
The observation comes after recent survey findings show the majority of European consumers believe meat alternatives with improved taste and lower price must be developed. These are key factors in convincing consumers to try plant-based meat.

“Consistently, the things that come out are taste and price at the top,” said Mayers, who was speaking at Food Ingredients Europe (FiE) in Frankfurt, in November.
“Those are the two things which are currently the barriers. We believe right now, that if taste were the same or better. If price were the same or lower for alternative proteins, they kind of become the default.”
Mayers, who was referencing a UBS Survey of over 3,000 US and European consumers in his presentation, added that the survey also identified nutrition as a close third, pointing out that consuming plants was better heath-wise than animal-based foods.
The shift by traditional meat firms to protein companies
While the presentation went on to discuss Unilever’s €1bn commitment to plant-based meat and dairy alternatives by 2027 and Nestle’s recent work with Future Meat Technologies, Mayers pointed to the repositioning of traditional meat firms into protein companies as “seeing the opportunity and where the future lies in their markets.”
This includes Tyson Foods’ recent launch of two plant-based brands Raised & Rooted and First Pride, coupled with the acquisition of BRF’s European operations in 2019. Its former CEO, Tom Hayes has said that, “If we can grow the meat without the animal, why wouldn't we?”
Fellow meat packing giant JBS has begun building the world’s largest cultivated beef protein plant in San Sebastián, Spain, which the firm believes will transform the company into global cultivated protein leader.
Myer’s presentation entitled: ‘Feeding the future: The alternative protein landscape,’ also discussed long-term investment growth, with GFI analysis of data from PitchBook Data, indicating that alternative protein investments totalled €2.66bn ($2.9 bn) in 2022, down 42% versus 2021.
“That decline tracked with the broader private investment environment,” said Mayers. “The drop in alternative proteins was only slightly larger than the 35% decrease in total global funding across all sectors in 2022.
“It was also smaller than the declines of some popular VC-funded sectors like fintech, which fell 46% year-over-year.”
Venture capitalist dip in meat alternative investments
Trends influencing these global investment declines included falling public equity markets, rising interest rates due to high inflation, ongoing impacts of the pandemic, and the invasion of Ukraine, which all contributed to reduced investment activity across sectors in 2022.
Added to the alt-proteins’ relative age, Mayers said that only a handful of large raises could heavily influence the topline investment numbers.
In 2022, for example, 3% of deals accounted for half of total investment dollars in alt proteins. So in a sector this size, one investment can have significant implications for year-to-year variations in investment totals.
“Over the longer-term, cumulative investments in alternative proteins in the last decade reached €12.8bn ($14bn). So, on average, alt protein investments nearly doubled every year over that span,” Mayers added.
In keeping an eye on the future, Mayers emphasised the role of traditional, biomass, and precision fermentation in alternative proteins, as processes that are likely to produce the protein at scale to meet expected demand.
While traditional fermentation is used to make sauerkraut, kimchi, and beer and is the most familiar to consumers, it is of little use in creating specific, high value functional ingredients.
© iStock/JK1991
© iStock/JK1991
Here’s where precision fermentation comes in, which can be used to engineer things like enzymes, flavouring agents, proteins, vitamins, natural pigments, and fats.
Precision fermentation ‘powerful enabler’ of improved sensory and functional attributes
“The ingredients these ‘microbial cell factories.’ produce are typically high value ingredients, incorporated at lower levels, but are powerful enablers of improved sensory and functional attributes,” explained Mayers.
“For example, we are seeing a number of companies using precision fermentation to produce recombinant whey protein that can be incorporated into plant based dairy formulations.
“Precision fermentation can also be used to create things like growth factors that are used in cultivated meat production.”
Mayers went on to discuss biomass fermentation, which uses the microorganism itself as a source of food, here by leveraging the fast growth and high protein content of a microorganism to efficiently produce large quantities of protein.
He said that the technique, which is used to make mycoprotein-based Quorn, offered the greatest opportunity to produce protein at scale because many microorganisms can grow very quickly and efficiently, often doubling their weight in just a few hours.
Related news

Tagatose exempt from added sugar labelling in US
19 May 2026
Tagatose, a low-calorie, natural sweetener with EU-approved health claims, is now exempt from added sugar labelling in the US – a move that could see uptake scale significantly.
Read more
Walmart revamps its ‘Great Value’ private label range
18 May 2026
US retail giant Walmart has rebranded its flagship ‘Great Value’ range, highlighting the quality and affordability of around 10,000 private label products.
Read more
Fairtrade International calls on industry to act for fair supply chains
14 May 2026
Via its Global Strategy 2026-2028, Fairtrade International is calling on the food industry to embed fairer sourcing practices and invest in long-term supplier relationships.
Read more
Which technologies can reduce damage and losses in the supply chain?
11 May 2026
Goods are often damaged throughout the supply chain but novel technologies – such as hyperspectral imaging, automated reject systems, and smart indicators – are reducing losses.
Read more
What are the biggest food health trends for 2026?
7 May 2026
Protein, gut health, functional beverages, and mental wellbeing are the key health-powered trends driving innovation and growth, says Innova Market Insights.
Read more
Biscuits and chocolate: Mondelēz targets 'resilient' categories for US and Europe growth
7 May 2026
Mondelēz International wants to bolster business further in developed markets, focusing on biscuits in the US and chocolate in Europe, as snacking continues to gain momentum globally, its CEO says.
Read more
Nutri-Score now more compatible with NOVA processed foods classification
5 May 2026
The European front-of-pack nutrition logo, Nutri-Score, is now better aligned with the processed food classification NOVA, following a 2026 algorithm update.
Read more
Harvard and Yuka uncover the hidden costs of cheap food
4 May 2026
The cheapest products contain 2.6 more additives and 21% more sugar than higher-priced products, according to a US study by Harvard and food scanning app Yuka.
Read more
UNICEF issues toolkit on child-focused food marketing
1 May 2026
Global organisation UNICEF has released a best practice toolkit on children’s rights and digital marketing, calling on policymakers and industry to stop unhealthy ads.
Read more
Unibio to open ‘world’s largest’ single-cell protein plant in Saudi Arabia
29 Apr 2026
Unibio is forging ahead with plans to open the “world’s largest” single-cell protein plant in Saudi Arabia. “The Middle East conflict has reinforced how critical local food production is,” says its CEO.
Read more